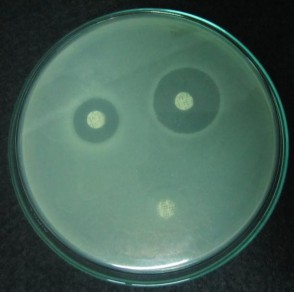
cefuroxim 12 mm clindamycin 0 mm erythromycin 16 mm levofloxacin 9 mm tetracyclin 10 mm 1
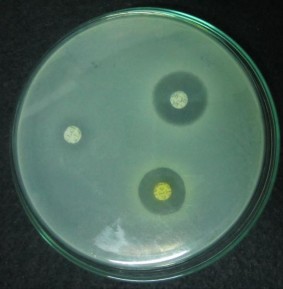
cefuroxim 12 mm clindamycin 0 mm erythromycin 16 mm levofloxacin 9 mm tetracyclin 10 mm 2

nghiệm catalase, khả năng sinh indol, khả năng làm dịch hóa gelatin, khả năng phản ứng nitrat hóa.
4.1.2.3. Kết quả nuôi cấy vi khuẩn Propionibacterium acnes
Qua khảo sát 100 mẫu bệnh phẩm của bệnh nhân mụn trứng cá lấy từ bệnh viện Da liễu Cần Thơ và phòng khám Tiến sĩ–Bác sĩ Huỳnh Văn Bá nuôi cấy, phân lập và định danh thu được kết quả như sau:
Bảng 4.10 Kết quả nuôi cấy Propionibacterium acnes
Số lượng (người) | Tỉ lệ (%) | |
Dương tính | 45 | 45 |
Âm tính | 55 | 55 |
Tổng | 100 | 100 |
Có thể bạn quan tâm!
-
Tình Hình Sử Dụng Kháng Sinh Và Đề Kháng Kháng Sinh Hiện Nay -
Đặc Điểm Nhóm Bệnh Nhân Mụn Trứng Cá Nghiên Cứu -
Kết Quả Định Danh Các Dòng Vi Khuẩn Phân Lập Được Bằng Phương Pháp Sinh Hóa -
Họ Tên Bênh Nhân:………………………………………………………………………. 2.giới Tính: -
Vì Sao Anh/chị Biết Đến Kem (Mỹ Phẩm) Mình Đang Sử Dụng ? -
Khảo sát tình hình đề kháng kháng sinh của vi khuẩn gây bệnh mụn trứng cá Probionibacterium acnes tại thành phố Cần Thơ - 10
Xem toàn bộ 108 trang tài liệu này.
Nhận xét: tỉ lệ hiện mắc Propionibacterium acnes ở các bệnh nhân mụn trứng cá trong 100 mẫu bệnh phẩm là 45 %.
4.1.2.4. Mối quan hệ giữa kết quả phân lập các dòng vi khuẩn Propionibacterium acnes và một số yếu tố khảo sát
Bảng 4.11 Mối liên hệ giữa kết quả phân lập các dòng vi khuẩn Propionibacterium acnes và yếu tố da nhờn
Có P. acnes
Da nhờn
n ( %)
Không có P.acnes N ( %)
x2 p
Có 31 (68,9%) 21 (38,2%)
Không 14 (31,1%) 34 (61,8%)
9,350 0,002
Nhận xét: có mối liên hệ giữa kết quả phân lập các dòng vi khuẩn
Propionibacterium acnes và yếu tố da nhờn của bệnh nhân mụn trứng cá (p=0.296). Bảng 4.12 Mối liên hệ giữa kết quả phân lập các dòng Propionibacterium acnes và mức độ bệnh mụn trứng cá
Có P. acnes n ( %) | Không có P. acnes n ( %) | x2 | p | |
Nhẹ Trung bình Nặng Rất nặng | 12 (26,7 %) 25 (55,6 %) 6 (13,3 %) 2 (4,4 %) | 15 (27,3 %) 34 (61,8 %) 6 (10,9 %) 0 (0 %) | 2,734 | 0,435 |
Nhận xét: không có mối liên hệ giữa kết quả phân lập các dòng
Propionibacterium acnes và mức độ bệnh mụn trứng cá (p=0,435).
Bảng 4.13 Mối liên hệ giữa kết quả phân lập các dòng Propionibacterium acnes và biểu hiện lâm sàng của bệnh nhân mụn trứng cá
Có P. acnes n ( %) | Không có P. acnes n ( %) | x2 | p | |
Trứng cá đỏ Mụn mủ và trứng cá đỏ Sẩn viêm Đỏ da, giãn mao mạch Trứng cá thông thường Khác | 8 (17,8 %) 16 (35,6 %) 6 (13,3 %) 3 (6,7 %) 10 (22,2 %) 2 (4,4 %) | 13 (23,6 %) 16 (29,1 %) 9 (16,4 %) 1 (1,8 %) 10 (18,2 %) 11 (11 %) | 3,829 | 0,574 |
Nhận xét: không có mối liên hệ giữa kết quả phân lập các dòng Propionibacterium acnes và biểu hiện lâm sàng của bệnh nhân mụn trứng cá (p=0,574).
Bảng 4.14 Mối liên hệ giữa kết quả phân lập các dòng Propionibacterium acnes và tiền sử điều trị của bệnh nhân mụn trứng cá
Có P. acnes n ( %) | Không có P. acnes n ( %) | x2 | P | |
Có Không | 38 (84,4 %) 7 (15,6 %) | 47 (85,5 %) 8 (14,5 %) | 0,02 | 0,888 |
Nhận xét: không có mối liên hệ giữa kết quả phân lập các dòng
Propionibacterium acnes và tiền sử điều trị của bệnh nhân mụn trứng cá (p=0,888).
4.1.3. Kết quả khảo sát khả năng ức chế vi khuẩn Propionibacterium acnes của một số loại kháng sinh
Khảo sát khả năng nhạy cảm của 45 dòng vi khuẩn P. acnes với 6 loại kháng sinh, sau 48 giờ ở mỗi đĩa kháng sinh xuất hiện vòng vô khuẩn xác định độ nhạy của vi khuẩn.
Đường kính vòng vô khuẩn được đọc theo tiêu chuẩn của từng loại kháng sinh được công bố của công ty Nam Khoa để đánh giá mức độ nhạy cảm kháng sinh của các dòng vi khuẩn phân lập. Tính nhạy cảm của các dòng vi khuẩn phân lập đối với 6 loại kháng sinh được xác định dựa vào đường kính vòng vô khuẩn được trình bày qua bảng (Bảng 3.2).
Khả năng nhạy cảm của 45 dòng vi khuẩn P. acnes với các loại kháng sinh tổng hợp clindamycin, levofloxacin, erythromycin, cefuroxim, tetracyclin, trimethoprim/sulfamethoxazol, thu được kết quả trình bày ở bảng sau:
Bảng 4.15 Kết quả kháng sinh đồ đối với vi khuẩn P. acnes
Trung gian | Nhạy | |||||
Kháng sinh | Số dòng | Tỉ lệ (%) | Số dòng | Tỉ lệ (%) | Số dòng | Tỉ lệ (%) |
Clindamycin | 45 | 100 | 0 | 0,0 | 0 | 0,0 |
Levofloxacin | 32 | 71,1 | 6 | 13,3 | 7 | 15,6 |
Erythromycin | 40 | 88,9 | 4 | 8,9 | 1 | 2,2 |
Trimethoprim/sulfamethoxazol | 43 | 95,6 | 2 | 4,4 | 0 | 0,0 |
Cefuroxim | 26 | 57,8 | 11 | 24,4 | 8 | 17,8 |
Tetracyclin | 44 | 97,8 | 1 | 2,2 | 0 | 0,0 |
120
100
100
88,9
95,6
97,8
80
71,1
57,8
60
40
20
0
tỉ lệ đề kháng (%)
Clindamycin
Levofloxacin
Erythromycin
Trimethoprim/sulfamethoxazole
Cefuroxim
Tetracyclin
Hình 4.8 Biểu đồ thể hiện tỉ lệ đề kháng kháng sinh của P.acnes
Nhận xét: trong số 45 dòng P. acnes khảo sát, có tỉ lệ đề kháng với các loại kháng sinh như sau: clindamycin 100 %; levofloxacin 71,1 %; erythromycin 88,9 %; trimethoprim/sulfamethoxazol 95,6 %; cefuroxim 57,8 %; tetracyclin 97,8 %.

cefuroxim | 12 mm |
clindamycin | 0 mm |
erythromycin | 16 mm |
levofloxacin | 9 mm |
tetracyclin | 10 mm |
trimethoprim/sulfamethoxazol | 0 mm |
Hình 4.9 Kết quả kháng sinh đồ vi khuẩn P. acnes dòng 165N sau 48 giờ Đường kính vòng vô khuẩn:
4.2 THẢO LUẬN
4.2.1. Đặc điểm nhóm bệnh nhân mụn trứng cá nghiên cứu
Trong số 100 trường hợp bệnh nhân mụn trứng cá, bệnh nhân nam chiếm 23
%, bệnh nhân nữ chiếm 77 %.
Kết quả nghiên cứu này tương tự với nghiên cứu của Nguyễn Thanh Hùng và Nguyễn Tất Thắng, (2013) bệnh nhân nữ chiếm tỉ lệ 67,8 % và nam 32,2 %. Tương tự nghiên cứu của Phạm Thu Hiền và ctv, (2011) bệnh nhân nữ chiếm tỉ lệ 62 % và nam 38 %. Điều này không có nghĩa là bệnh mụn trứng cá thường gặp ở nữ mà tỉ lệ bệnh nhân nữ bị mụn trứng cá cao hơn bệnh nhân nam do bệnh nhân nữ quan tâm đến tình trang bệnh, yếu tố thẩm mỹ và luôn mong muốn cải thiện tình trạng da của mình nên bệnh nhân nữ tìm đến cơ sở điều trị nhiều hơn so với bệnh nhân nam.
Bệnh chủ yếu gặp ở độ tuổi 19–25 chiếm tỉ lệ cao nhất 51 % tương tự với nghiên cứu của Phạm Thu Hiền và ctv, (2011), thấp hơn nghiên cứu của Phùng Thị Yến Thanh, (2015) nhóm trên 19 tuổi chiếm 70 %.
Nhóm tuổi 19–25 chiếm tỉ lệ cao nhất vì đây là lứa tuổi có khả năng mắc bệnh mụn trứng cá nhiều nhất do còn độ tuổi dậy thì. Giai đoạn sớm của tuổi dậy thì có sự gia tăng androgen của thượng thận và androgen sinh dục, những androgen này kích thích sự tăng tiết của tuyến bã nhờn. Giai đoạn này ảnh hưởng nhiều đến yếu tố thẩm
mỹ, nhu cầu giao tiếp, ngoại hình để có nhiều cơ hội phát triển tốt hơn trong công việc sau này. Đó là lý do những bệnh nhân này tìm đến cơ sở điều trị nhiều hơn so với các đối tượng khác.
Bệnh nhân ở nhóm học sinh–sinh viên chiếm tỉ lệ cao nhất 51 %, tiếp đó là nhân viên văn phòng chiếm 18 %. Kết quả nghiên cứu này tương tự nghiên cứu của Nguyễn Thanh Hùng và Nguyễn Tất Thắng, (2013) nhóm Đại học Cao đẳng sau đại học chiếm 60,9 %. Thấp hơn nghiên cứu của Phạm Thu Hiền và ctv, (2011) nhóm Đại học, Cao đẳng chiếm 94 %. Cao hơn nghiên cứu của Phùng Thị Yến Thanh, (2015) nhóm học sinh, sinh viên chiếm 40 %. Tỉ lệ nhóm học sinh– sinh viên chiếm 51 %, tiếp đến là nhân viên văn phòng 18 % vì đây là lứa tuổi có tần suất mắc bệnh mụn trứng cá nhiều nhất.
Những đối tượng này là học sinh- sinh viên và nhân viên văn phòng nên thường căng thẳng tâm lý do học tập và công việc, rối loạn thể chất, rối loạn nội tiết tố. Ngoài ra đây là lứa tuổi bắt đầu có nhiều mối quan hệ tình bạn, tình yêu… đối tượng có nhu cầu giao tiếp và lưu ý đến ngoại hình rất nhiều để có cơ hội phát triển và thăng tiến trong công việc sau này, các bệnh nhân này tìm đến cơ sở điều trị nhiều hơn các đối tượng khác.
Bệnh nhân ở mức độ nhẹ và trung bình chiếm tỉ lệ cao nhất lần lượt là 27 % và 59 %. Tương tự nghiên cứu của Phạm Thu Hiền ctv (2011) bệnh chủ yếu ở mức độ vừa và nhẹ chiếm 48 % và 40 %.
Bệnh nhân da nhờn chiếm tỉ lệ cao nhất 52 %, tiếp đó là da hỗn hợp chiếm 21
%. Tương tự nghiên cứu của Nguyễn Thị Hồng Nhung và Lê Ngọc Diệp (2014) da nhờn chiếm tỉ lệ cao nhất 78,4 %; da hỗn hợp chiếm 16,7 %. Điều này phù hợp với cơ chế bệnh sinh của bệnh mụn trứng cá.
Theo nghiên cứu mụn mủ và trứng cá đỏ chiếm tỉ lệ cao nhất 32 %. Theo nghiên cứu của Nguyễn Thị Hồng Nhung và Lê Ngọc Diệp (2014) trứng cá sẩn và mụn mủ chiếm 37 %.
Trong tổng số 100 bệnh nhân mụn trứng cá khảo sát tỉ lệ bệnh nhân có tiền sử điều trị tại y tế tư chiếm tỉ lệ cao nhất 52 %, y tế công chiếm tỉ lệ thấp nhất là 5 %. Bệnh nhân có tiền sử điều trị tại Y tế tư chiếm tỉ lệ cao nhất do thuận tiện hơn về thời gian do nhóm bệnh nhân khảo sát chủ yếu là học sinh–sinh viên và nhân viên văn phòng.
4.2.2. Phân lập và định danh các dòng vi khuẩn Propionibacterium acnes từ da bệnh nhân mụn trứng cá
- Đặc điểm hình thái các dòng vi khuẩn phân lập
Trong tổng số 45 dòng vi khuẩn phân lập, phần lớn tế bào của các dòng vi khuẩn phân lập có hình dạng que ngắn với 29 dòng vi khuẩn có hình dạng que ngắn
chiếm 64,4 % và 16 dòng có hình dạng que dài chiếm 35,6 % (Bảng 4.8). Tương tự nghiên cứu Phùng Thị Yến Thanh, (2015) phần lớn tế bào của các dòng vi khuẩn phân lập có hình dạng que ngắn chiếm 87,5 % và que dài chiếm 12,5 %
- Định danh các dòng vi khuẩn phân lập được bằng phương pháp sinh hóa
Qua kết quả kiểm tra một số đặc điểm hình thái (Bảng 4.8) và đặc tính sinh hóa (Bảng 4.9) của các dòng vi khuẩn phân lập cho thấy 45 dòng vi khuẩn phân lập được là vi khuẩn P. acnes được thể hiện qua những đặc điểm sau:
+ Trên môi trường TYEG agar có bổ sung 0,002 % bromocresol purple sau 5–7 ngày (khuẩn lạc phát triển chậm), nhiệt độ 37 oC, pH 5–8, điều kiện kỵ khí khuẩn lạc có dạng hình tròn, bìa nguyên, nhô cao hoàn toàn trên bề mặt môi trường, màu vàng nhạt hoặc đậm.
+ Các dòng vi khuẩn đều có dạng hình que, Gram dương, không bào tử, catalase dương tính, indol dương tính, khả năng dịch hóa gelatin dương tính, khả năng phản ứng nitrat hóa dương tính.
- Kết quả nuôi cấy vi khuẩn Propionibacterium acnes
Tỉ lệ hiện mắc Propionibacterium acnes ở các bệnh nhân bệnh mụn trứng cá trong 100 mẫu bệnh phẩm là 45 % ( Bảng 4.10).
Tỉ lệ này tương tự với nghiên cứu của Nguyễn Thanh Hùng và Nguyễn Tất Thắng, (2013) tỉ lệ phân lập vi khuẩn là 48,3 %. Thấp hơn nghiên cứu của Phùng Thị Yến Thanh, (2015) số mẫu bệnh phẩm có sự hiện diện của P. acnes chiếm tỉ lệ 60 %.
- Mối liên hệ giữa kết quả phân lập các dòng vi khuẩn Propionibacterium acnes và yếu tố da nhờn.
Có mối liên hệ giữa kết quả phân lập các dòng vi khuẩn Propionibacterium acnes và yếu tố da nhờn của bệnh nhân (p=0.296). Kết quả này không phù hợp với kết quả nghiên cứu của Nguyễn Thanh Hùng và Nguyễn Tất Thắng, (2013).
Tỉ lệ bệnh nhân mụn trứng cá có da nhờn nuôi cấy được P. acnes là 68,9 %, cao hơn tỉ lệ bệnh nhân không có da nhờn nuôi cấy được P. acnes là 31,1 %. Kết quả này phù hợp với nhiều nghiên cứu khác cho thấy rằng da nhờn là yếu tố quan trọng cho sự tăng sinh và phân bố của P. acnes. Những bệnh nhân có da nhờn hơn sẽ cung cấp một môi trường dinh dưỡng tốt hơn, số lượng P. acnes nhiều hơn, do đó khả năng phát hiện và phân lập vi khuẩn P. acnes sẽ tăng. Với bệnh phẩm được lấy từ bã và nhân mụn, sẽ dễ dàng bắt được P. acnes với số lượng lớn đang phát triển trong đó.
- Mối liên hệ giữa kết quả phân lập các dòng Propionibacterium acnes và mức độ bệnh mụn trứng cá.
Không có mối liên hệ giữa kết quả phân lập các dòng Propionibacterium acnes
và mức độ bệnh mụn trứng cá (p=0,435).
Kết quả này phù hợp vời kết quả nghiên cứu của Nguyễn Thanh Hùng và Nguyễn Tất Thắng, (2013). Số lượng vi khuẩn P. acnes không liên quan đến mức độ nặng của bệnh mụn trứng cá.
- Mối liên hệ giữa kết quả phân lập các dòng Propionibacterium acnes và biểu hiện lâm sàng của bệnh nhân mụn trứng cá.
Không có mối liên hệ giữa kết quả phân lập các dòng Propionibacterium acnes
và biểu hiện lâm sàng của bệnh nhân mụn trứng cá (p=0,574).
- Mối liên hệ giữa kết quả phân lập các dòng Propionibacterium acnes và tiền sử điều trị của bệnh nhân mụn trứng cá.
Không có mối liên hệ giữa kết quả phân lập các dòng Propionibacterium acnes
và tiền sử điều trị của bệnh nhân mụn trứng cá (p=0,888).
Kết quả này phù hợp vời kết quả nghiên cứu của Nguyễn Thanh Hùng và Nguyễn Tất Thắng, (2013).
4.2.3. Kết quả khảo sát khả năng ức chế vi khuẩn Propionibacterium acnes của một số loại kháng sinh
Khảo sát khả năng nhạy cảm của 45 dòng vi khuẩn P. acnes với 6 loại kháng sinh, có tỉ lệ đề kháng như sau: clindamycin 100 %; levofloxacin 71,1 %; erythromycin 88,9 %; trimethoprim/sulfamethoxazol 95,6 %; cefuroxim 57,8 %;
tetracyclin 97,8 %.
Kết quả nghiên cứu này tương tự với Nguyễn Thanh Hùng và Nguyễn Tất Thắng, (2013) tỉ lệ P. acnes đề kháng trimethoprim/sulfamethoxazol là 95,2 %; clindamycin là 88,1 % và khác biệt tỉ lệ đề kháng tetracyclin, levofloxacin, cefuroxim là 0 %.
Mỗi loại kháng sinh có những đặc điểm dược động học, phổ kháng khuẩn, tình hình sử dụng kháng sinh trên lâm sàng và cơ chế đề kháng khác nhau.
Trong nhiên cứu này tỉ lệ đề kháng của vi khuẩn gây mụn trứng cá P. acnes với
5 loại kháng sinh clindamycin, levofloxacin, erythromycin, tetracyclin, trimethoprim/sulfamethoxazol đều rất cao. Sự đề kháng này là do sự quản lý không chặt chẽ các loại kháng sinh, kháng sinh có thể mua tại các nhà thuốc rất dễ dàng mà không cần đơn thuốc. Sự đề kháng của kháng sinh gia tăng là do đơn thuốc sử dụng các phác đồ kết hợp kháng sinh đường uống và đường thoa cùng một loại nhiều hơn so với khác loại. Sản phẩm clindamycin, erythromycin được bào chế dưới nhiều dạng uống, thoa tại chỗ dạng đơn chất hay kết hợp trong điều trị mụn trứng cá là rất phổ biến.
Các loại kháng sinh được sử dụng rộng rãi góp phần làm thay đổi thảm vi khuẩn da gây ra đề kháng chéo. Sự đề kháng của P. acnes còn do lây nhiễm qua tiếp xúc với người mắc mụn trứng cá mang chủng vi khuẩn kháng thuốc.






